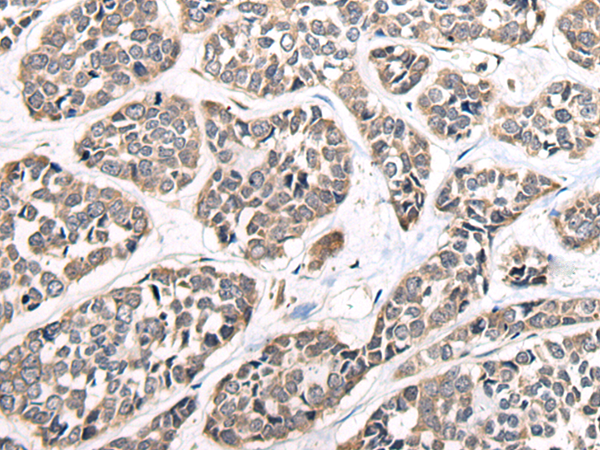

别名:KRP; AAT7; MLCK; MLCK1; MYLK1; smMLCK; MLCK108; MLCK210; MSTP083应用:IHC
反应种属:Human, Mouse
规格:50μl/100μl
| Description |
|---|
| This gene, a muscle member of the immunoglobulin gene superfamily, encodes myosin light chain kinase which is a calcium/calmodulin dependent enzyme. This kinase phosphorylates myosin regulatory light chains to facilitate myosin interaction with actin filaments to produce contractile activity. This gene encodes both smooth muscle and nonmuscle isoforms. In addition, using a separate promoter in an intron in the 3′ region, it encodes telokin, a small protein identical in sequence to the C-terminus of myosin light chain kinase, that is independently expressed in smooth muscle and functions to stabilize unphosphorylated myosin filaments. A pseudogene is located on the p arm of chromosome 3. Four transcript variants that produce four isoforms of the calcium/calmodulin dependent enzyme have been identified as well as two transcripts that produce two isoforms of telokin. Additional variants have been identified but lack full length transcripts. |
| Specification | |
|---|---|
| Aliases | KRP; AAT7; MLCK; MLCK1; MYLK1; smMLCK; MLCK108; MLCK210; MSTP083 |
| Swissprot | Q15746 |
| Host/Isotype | Rabbit IgG |
| Storage | Store at 4°C short term. Aliquot and store at -20°C long term. Avoid freeze/thaw cycles. |
| Species Reactivity | Human, Mouse |
| Immunogen | Synthetic peptide of human MYLK |
| Formulation | pH7.4 PBS, 0.05% NaN3, 40% Glycerol |
| Application | |
|---|---|
| IHC | 1/25-1/100 |
| ELISA | 1/5000-1/10000 |
 |
The image is immunohistochemistry of paraffin-embedded Human liver cancer tissue using P05705(MYLK Antibody) at dilution 1/25. (Original magnification: ×200) |
|
The image is immunohistochemistry of paraffin-embedded Human esophagus cancer tissue using P05705(MYLK Antibody) at dilution 1/25. (Original magnification: ×200) |
本公司的所有产品仅用于科学研究或者工业应用等非医疗目的,不可用于人类或动物的临床诊断或治疗,非药用,非食用。
暂无评论
本公司的所有产品仅用于科学研究或者工业应用等非医疗目的,不可用于人类或动物的临床诊断或治疗,非药用,非食用。
 中文
中文 








发表回复